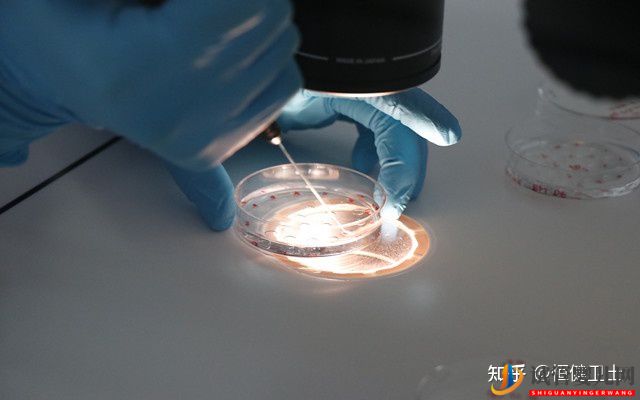

做三代试管大约多少钱一次
(+Q:914935817)目前国内做三代试管的价格在10-16万左右。国外比如泰国费用在15-20万左右。但是现在的疫情情况,大多数人可能在国内做三代。所以至少准备15万,预备最好多一点,有备无患。


影响三代试管费用的三个因素
第一种:年龄
如果说你年轻,年龄大概在25-33岁左右,卵巢功能较好,卵泡的数量和质量是有保障的,成功率就会高一些,只需花费一个试管周期的钱即可。如果你的年纪大,卵巢功能严重下降,卵泡难以发育,用药多,那自然就贵。
第二种:试管技术
如果你在三代试管过程中,还需使用到卵胞浆内单J子注射(二代试管),(+Q:914935817)那么费用也会增加。
第三种:医院的选择
我们知道,医院有公立和私立,公立是非营利性的,而私立呢是营利性的,公立医院要有指征,大多数人不能做的,而私立有绿色通道比较容易,但是,花费也比较高。
如何一步一步提高试管成功几率?
第一个首先是卵子的品质
卵子是试管最基础的物质之一,质量越高,那么后面配对成胚胎的数量和等级就有越高的机会,最好的办法就是尽量选择合适的年龄进行试管,女人超过35岁,卵子品质开始老化,成功几率会打折,所以呢做试管要越早越好。

(+Q:914935817)第二个是子宫内膜的品质
子宫内膜是胚胎成长、发育的重要场所,内膜如果适合、血流丰富而且细胞分裂良好,会增加着床率,移植前如果内膜不达标,可以先将胚胎冷冻,等情况合适后再植入,可以增加试管成功的几率。
胚胎植入之后要适当的卧床休息,以及补充足够的黄体酮,以增加着床率减少宫外孕的比率。
第三个是胚胎植入手术
胚胎培育好之后,要移植回女性的子宫,这个过程决定着试管婴儿能否正常着床。如果医生将胚胎放在容易着床的位置,可增加成功几率,因此经验丰富、技术精湛的专家很重要。





